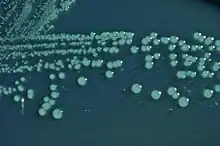

Shigella boydii
| Shigella boydii | |
|---|---|
| |
| Shigella boydii on Hektoen enteric agar | |
| Scientific classification | |
| Domain: | Bacteria |
| Kingdom: | Pseudomonadati |
| Phylum: | Pseudomonadota |
| Class: | Gammaproteobacteria |
| Order: | Enterobacterales |
| Family: | Enterobacteriaceae |
| Genus: | Shigella |
| Species: | S. boydii
|
| Binomial name | |
| Shigella boydii Ewing 1949
| |
Shigella boydii is a Gram-negative bacterium of the genus Shigella. Like other members of the genus, S. boydii is a nonmotile, nonsporeforming, rod-shaped bacterium which can cause dysentery in humans through fecal-oral contamination.[1]
Shigella boydii is the most genetically divergent species of the genus Shigella.[2] There are 19 known serotypes of Shigella boydii.[3][4][5] S. boydii is restricted to the Indian subcontinent.[4]
The species is named after the British bacteriologist John Boyd.[6]
Sequenced genomes
- Shigella boydii strain BS512 (serotype 18; group 1) has one chromosome and five plasmids.

References
- ↑ Ryan, Kenneth James; Ray, C. George, eds. (2004). Sherris medical microbiology: an introduction to infectious diseases (4 ed.). McGraw-Hill Professional Med/Tech. ISBN 978-0-8385-8529-0.
- ↑ Feng L; Senchenkova SN; Yang J; Shashkov AS; Tao J; Guo H; Zhao G; Knirel YA; Reeves P; Wang L (2004). "Structural and Genetic Characterization of the Shigella boydii Type 13 O Antigen". Journal of Bacteriology. 186 (2): 383–392. doi:10.1128/JB.186.2.383-392.2004. PMC 305744. PMID 14702307.
- ↑ Yang Z., Hu C., Chen J., Chen G., Liu Z. (1990). A new serotype of Shigella boydii. Wei Sheng Wu Xue Bao.; 30(4): 284-95
- ↑ 4.0 4.1 Yang F, Yang J, Zhang X, et al. (2005). "Genome dynamics and diversity of Shigella species, the etiologic agents of bacillary dysentery". Nucleic Acids Research. 33 (19): 6445–6458. doi:10.1093/nar/gki954. PMC 1278947. PMID 16275786.
- ↑ Pupo GM; Lan R; Reeves PR (September 2000). "Multiple independent origins of Shigella clones of Escherichia coli and convergent evolution of many of their characteristics". Proc. Natl. Acad. Sci. U.S.A. 97 (19): 10567–72. Bibcode:2000PNAS...9710567P. doi:10.1073/pnas.180094797. PMC 27065. PMID 10954745.
- ↑ "Species: Shigella boydii". lpsn.dsmz.de. Archived from the original on 2022-10-04. Retrieved 2022-08-19.
External links
- Shigella boydii Genome Project Page Archived 2023-07-18 at the Wayback Machine — by Entrez
- "Shigella boydii". NCBI Taxonomy Browser. 621. Archived from the original on 2022-01-28. Retrieved 2022-08-19.
- Type strain of Shigella boydii at BacDive - the Bacterial Diversity Metadatabase Archived 2016-09-17 at the Wayback Machine